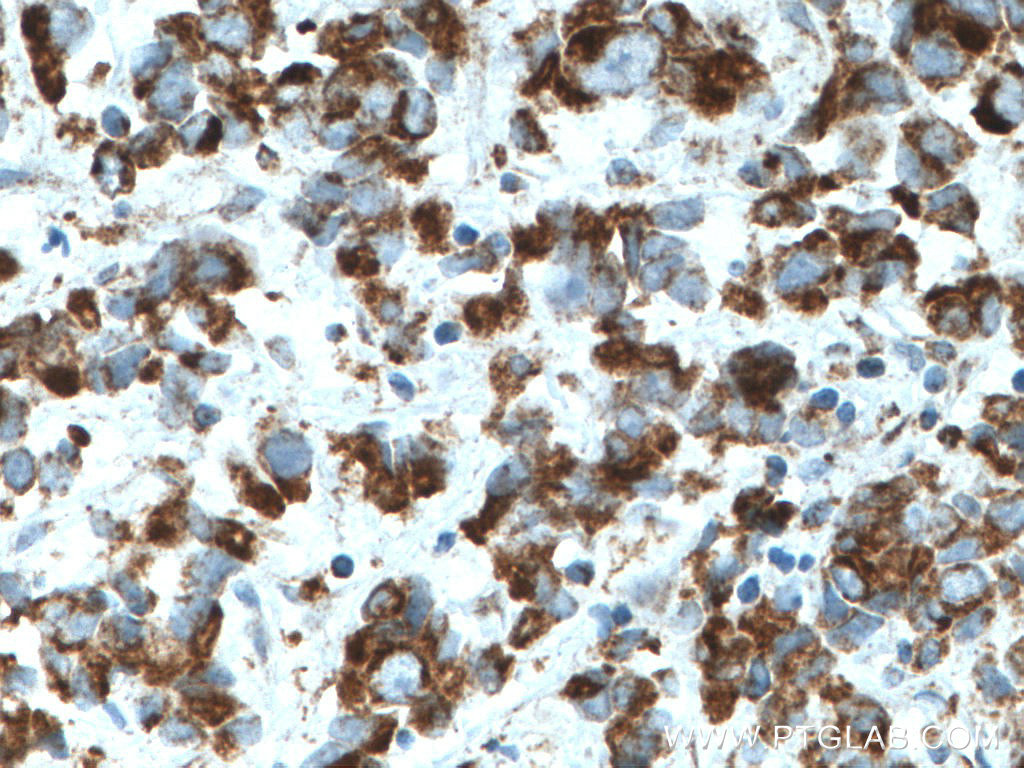

验证数据展示
经过测试的应用
| Positive WB detected in | HepG2 cells, PC-3 cells, Jurkat cells, K-562 cells, HSC-T6 cells, NIH/3T3 cells, U-251 cells, U-87 MG cells |
| Positive IHC detected in | human prostate cancer tissue, human colon cancer tissue Note: suggested antigen retrieval with TE buffer pH 9.0; (*) Alternatively, antigen retrieval may be performed with citrate buffer pH 6.0 |
| Positive IF/ICC detected in | HepG2 cells |
推荐稀释比
| 应用 | 推荐稀释比 |
|---|---|
| Western Blot (WB) | WB : 1:2000-1:10000 |
| Immunohistochemistry (IHC) | IHC : 1:500-1:2000 |
| Immunofluorescence (IF)/ICC | IF/ICC : 1:400-1:1600 |
| It is recommended that this reagent should be titrated in each testing system to obtain optimal results. | |
| Sample-dependent, Check data in validation data gallery. | |
产品信息
66776-1-Ig targets MFN1 in WB, IHC, IF/ICC, ELISA applications and shows reactivity with human, mouse, rat samples.
| 经测试应用 | WB, IHC, IF/ICC, ELISA Application Description |
| 文献引用应用 | WB, IHC, IF |
| 经测试反应性 | human, mouse, rat |
| 文献引用反应性 | human, mouse, rat, pig |
| 免疫原 |
CatNo: Ag4890 Product name: Recombinant human MFN1 protein Source: e coli.-derived, PET28a Tag: 6*His Domain: 27-351 aa of BC040557 Sequence: EFVTEGSHFVEATYKNPELDRIATEDDLVEMQGYKDKLSIIGEVLSRRHMKVAFFGRTSSGKSSVINAMLWDKVLPSGIGHITNCFLSVEGTDGDKAYLMTEGSDEKKSVKTVNQLAHALHMDKDLKAGCLVRVFWPKAKCALLRDDLVLVDSPGTDVTTELDSWIDKFCLDADVFVLVANSESTLMNTEKHFFHKVNERLSKPNIFILNNRWDASASEPEYMEDVRRQHMERCLHFLVEELKVVNALEAQNRIFFVSAKEVLSARKQKAQGMPESGVALAEGFHARLQEFQNFEQIFEECISQSAVKTKFEQHTIRAKQILATV 种属同源性预测 |
| 宿主/亚型 | Mouse / IgG2a |
| 抗体类别 | Monoclonal |
| 产品类型 | Antibody |
| 全称 | mitofusin 1 |
| 别名 | 3F11C11, EC:3.6.5.-, Fzo homolog, hfzo1, hfzo2 |
| 计算分子量 | 741 aa, 84 kDa |
| 观测分子量 | 84 kDa |
| GenBank蛋白编号 | BC040557 |
| 基因名称 | MFN1 |
| Gene ID (NCBI) | 55669 |
| RRID | AB_2882122 |
| 偶联类型 | Unconjugated |
| 形式 | Liquid |
| 纯化方式 | Protein A purification |
| UNIPROT ID | Q8IWA4 |
| 储存缓冲液 | PBS with 0.02% sodium azide and 50% glycerol, pH 7.3. |
| 储存条件 | Store at -20°C. Stable for one year after shipment. Aliquoting is unnecessary for -20oC storage. |
背景介绍
Mitofusin-1 (MFN1) is a mediator of mitochondrial fusion. This protein and mitofusin 2 are homologs of the Drosophila protein fuzzy onion (Fzo). Mitofusins are large predicted GTPases located in outer mitochondrial membrane. They are essential for outer membrane fusion by interacting with each other to facilitate mitochondrial targeting. The mitofusins are the first known protein mediator of mitochondrial fusion, and mediate developmentally regulated post-meiotic fusion of mitochondria. Mitofusin 1 and mitofusin 2 are ubiquitinated in a PINK1/parkin-dependent manner upon induction of mitophagy(PMID: 20871098).
实验方案
| Product Specific Protocols | |
|---|---|
| IF protocol for MFN1 antibody 66776-1-Ig | Download protocol |
| IHC protocol for MFN1 antibody 66776-1-Ig | Download protocol |
| WB protocol for MFN1 antibody 66776-1-Ig | Download protocol |
| Standard Protocols | |
|---|---|
| Click here to view our Standard Protocols |
发表文章
| Species | Application | Title |
|---|---|---|
Nat Commun BNIP3L/NIX-mediated mitophagy protects against glucocorticoid-induced synapse defects. | ||
Ecotoxicol Environ Saf Zinc deficiency compromises the maturational competence of porcine oocyte by inducing mitophagy and apoptosis | ||
J Cell Physiol DMT1 Maintains Iron Homeostasis to Regulate Mitochondrial Function in Porcine Oocytes | ||
Cytokine Role of FGF19 in regulating mitochondrial dynamics and macrophage polarization through FGFR4/AMPKα-p38/MAPK Axis in bleomycin-induced pulmonary fibrosis | ||
Molecules Nujiangexanthone A Inhibits Cervical Cancer Cell Proliferation by Promoting Mitophagy. | ||
Appl Biochem Biotechnol Astragaloside IV Relieves Mitochondrial Oxidative Stress Damage and Dysfunction in Diabetic Mice Endothelial Progenitor Cells by Regulating the GSK-3β/Nrf2 Axis |